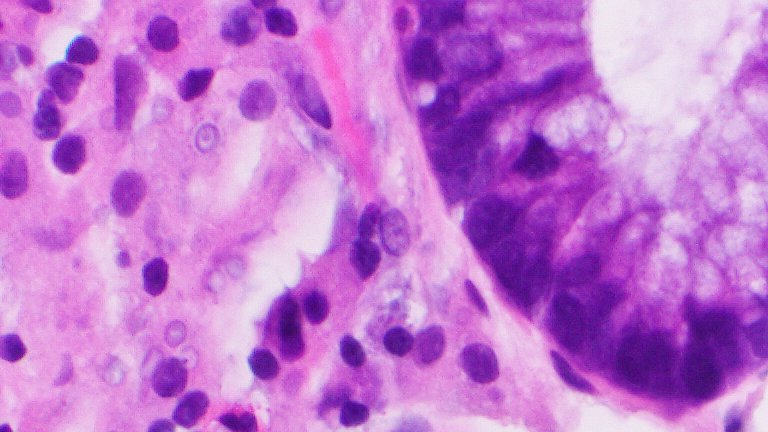
Our editor-in-chief has this treat! What do you guys think? PS A GI biopsy! @bhardwaj_swat <a href="/MLisaZhang/">M. Lisa Zhang, MD</a> <a href="/ALBoothMD/">Adam L. Booth, MD</a> <a href="/RunjanChetty/">Runjan Chetty</a>

Natasha Singh MD, FCAP, FASCP
@natashasinghmd
Attending @ SSM Health Alumni:Cytopathology @Columbia|GI/Liver @UNMC|ChiefResident AP/CP @RWJMS|PostDoc @Harvard|Board Certified - AP/CP.
ID: 1449875413732368393
https://www.linkedin.com/in/natasha-singh-md-b4a915214 17-10-2021 23:10:22
62 Tweet
88 Takipçi
238 Takip Edilen





I received my copy! Excellent textbook! Beautiful pictures 😀Xiaoyin "Sara" Jiang, MD (She/Her)


Our editor-in-chief has this treat! What do you guys think? PS A GI biopsy! @bhardwaj_swat M. Lisa Zhang, MD Adam L. Booth, MD Runjan Chetty

Oh please do take this survey! It’s about lymph nodes, and colon cancer. Our favourite topic! JClinPath_BMJ


Pathologists job market has flourished and will continue to do so! #CAP23 #HOD #RF session! Adam L. Booth, MD @bhardwaj_swat


Going to #CAP23 and like #GIpath? Make sure to attend our short course to learn about the latest in staging and local excisions of CRC, #neuronedocrine #pathology and #biomarker testing! Dipti karamchandani @jondavison CAPathologists BIDMC Pathology UTSW Department of Pathology UPMC Pathology


Haha modern day Cytopathology “FNA call-site specific emoji “#templerocks Temple Pathology Dina Zenezan,MD nj Nikolina Dioufa #cytopath#cytology


Sessile serrated lesion/adenoma caught in the act transforming into an invasive adenocarcinoma Please forgive me not adhering to the latest WHO nomenclature, posted for worldwide audience🙃 #PathTwitter #MedTwitter @wusm_pathology WashU Medicine Pathology & Immunology Education




Cleveland Clinic GI Pathologists wearing blue today for colorectal cancer awareness month!! Colorectal Cancer Alliance ClevelandClinicLabs #ColorectalCancerAwarenessMonth #DressInBlueDay



Great talks at the ASC and BAC Companion meeting by Drs. Blythe Gorman and Amy Ly discussing ROSE in the context of Pancreaticobiliary lesions and perspectives of an interventional cytopathologist Cytopathology.org


Ultrasound FNA teaching for our @dukepathdept #CytoPath Fellow Dr. Meg Lee! Interventional cytopathologists rock! DanielleElliottRange










